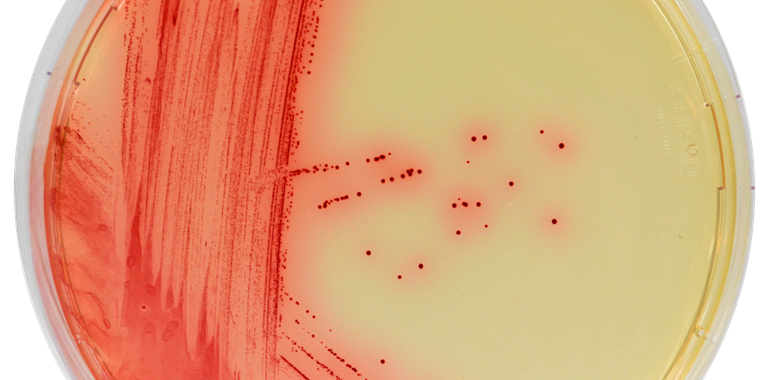

Entdecken Sie unser chromogenes Medium:
CHROMagar™
Mycoplasma
Chromogenes Medium zum Nachweis von Mycoplasma bovis.
Rinderinfektionen können zu einer Vielzahl von klinischen Symptomen führen, wie hauptsächlich Lungenentzündung, aber auch Arthritis, Mastitis und Keratokonjunktivitis, von denen keine M. bovis-spezifisch ist. Die Labordiagnostik ist daher wichtig.
Die Identifizierung von M. bovis aus Nasenabstrichen und bronchoalveolären Lavageproben kann durch direktes Ausstreichen der Probe auf CHROMagar™ Mycoplasma-Agarplatten erfolgen. Der Nachweis von M. bovis durch die Rotfärbung und die Spiegeleimorphologie der Kolonien unter der Binokularlupe ermöglicht einen einfachen Nachweis nach 3-7 Tagen Inkubation bei 37 °C unter CO2-Atmosphäre.
Vorteile des CHROMagar™ Mycoplasma:
- Einfach abzulesen und zu interpretieren
Mit CHROMagar™ Mycoplasma wachsen Mycoplasma-Kolonien in einer intensiven roten Färbung mit spiegeleiartigem Aussehen, was den Nachweis sehr vereinfacht. - Nachweis
Nachweis möglich innerhalb 3 bis 7 Tagen bei Inkubation unter CO2-Atmosphäre. - Einfach Methode
Der Nachweis von M. bovis aus Nasalabstrichen und bronchoalveolären Lavageproben erfolgt durch direktes Ausstreichen der Probe auf die Platte.
Den CHROMagar™ Mycoplasma erhalten Sie bei uns in der folgenden Variante:
CHROMagar™ Mycoplasma Trockennährmedium
(1 x 1 Liter, Art. Nr. 15MB640)